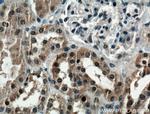
LSM8 Antibody in Immunohistochemistry (Paraffin) (IHC (P))

Search
Proteintech
LSM8 Polyclonal Antibody
{{$productOrderCtrl.translations['antibody.pdp.commerceCard.promotion.promotions']}}
{{$productOrderCtrl.translations['antibody.pdp.commerceCard.promotion.viewpromo']}}
{{$productOrderCtrl.translations['antibody.pdp.commerceCard.promotion.promocode']}}: {{promo.promoCode}} {{promo.promoTitle}} {{promo.promoDescription}}. {{$productOrderCtrl.translations['antibody.pdp.commerceCard.promotion.learnmore']}}
产品信息
10134-1-AP
种属反应
宿主/亚型
分类
类型
抗原
偶联物
形式
浓度
规格
纯化类型
保存液
内含物
保存条件
运输条件
产品详细信息
Immunogen sequence: MTSALENYI NRTVAVITSD GRMIVGTLKG FDQTINLILD ESHERVFSSS QGVEQVVLGL YIVRGDNVAV IGEIDEETDS ALDLGNIRAE PLNSVAH (1-96 aa encoded by B C002742)
靶标信息
This gene encodes a member of the like-Sm family of proteins. The encoded protein consists of a closed barrel shape, made up of five anti-parallel beta strands and an alpha helix. This protein partners with six paralogs to form a heteroheptameric ring which transiently binds U6 small nuclear RNAs and is involved in the general maturation of RNA in the nucleus.
仅用于科研。不用于诊断过程。未经明确授权不得转售。
生物信息学
蛋白别名: LSM8 homolog, U6 small nuclear RNA associated; LSM8 U6 small nuclear RNA associated; MAK31-like protein; N-alpha-acetyltransferase 38, NatC auxiliary subunit; U6 snRNA-associated Sm-like protein LSm8; unnamed protein product
基因别名: 2010003I05Rik; AW214405; LSM8; NAA38
UniProt ID: (Human) O95777, (Mouse) Q6ZWM4
Entrez Gene ID: (Human) 51691, (Mouse) 76522, (Rat) 296913